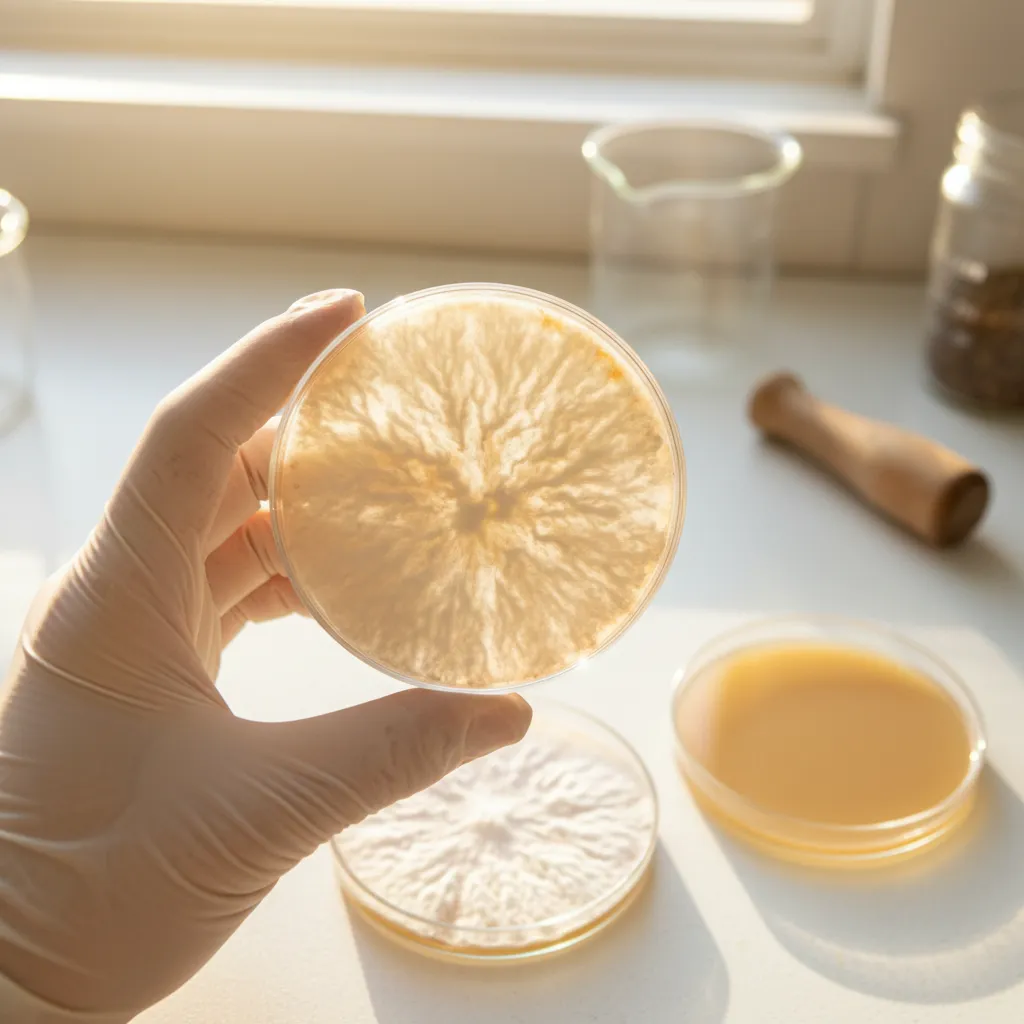
Pre-poured agar plates for mushroom culture work

Your cart is empty
Guides · Research · Recipes
Growing guides, species profiles, and research-backed health information from our Brantford, Ontario facility.
55 articles
 10 min read
10 min readComparing the Myco Labs, Excalibur 3900B, and COSORI dehydrators for drying mushrooms. Honest reviews from growers who dry weekly.
 11 min read
11 min readComparing Inkbird humidity controllers for mushroom fruiting chambers. WiFi vs standard vs combo temp+humidity, with honest opinions.
 11 min read
11 min readComparing 8-inch, 12-inch, and 16-inch impulse sealers for mushroom grow bags. Which size do you actually need? Our honest take.
 11 min read
11 min readComparing commercial flow hoods, compact units, and DIY builds for mushroom cultivation. Honest recommendations from working mycologists.
 9 min read
9 min readComparing the Presto 23-Qt, All American 921, and Presto 01784 for mushroom sterilization. Honest opinions from growers who use them daily.
 12 min read
12 min readEvery piece of mushroom cultivation equipment you need, organized by category. From pressure cookers to flow hoods, scales to sealers.
 14 min read
14 min readLearn the right spawn-to-substrate ratio for every species and method. Practical ratios for oyster, lion's mane, shiitake, and more.
 13 min read
13 min readComplete guide to chicken of the woods mushroom — identification, safety, foraging tips, cooking methods, and recipes for this popular wild mushroom.
 10 min read
10 min readLearn the G2G transfer technique to multiply mushroom spawn fast. Covers ratios, sterile technique, equipment, and troubleshooting tips.
 16 min read
16 min readComplete guide to growing mushrooms on logs in Canada. Log selection, plug spawn inoculation, totem method, species, timeline, and winter care.
 11 min read
11 min readLearn how to make mushroom liquid culture with honey. Complete recipe with ratios, pressure cooking, inoculation, and troubleshooting tips.
 11 min read
11 min readLearn mushroom cloning with this beginner tissue culture guide. Select the best genetics, take inner stem tissue, and grow on agar plates.
 13 min read
13 min readLearn to make grain spawn at home with rye, oats, or millet. Covers grain prep, sterilization, inoculation, and the budget Broke Boi method.
 11 min read
11 min readLearn to prepare CVG, hardwood, and straw bulk substrates for mushroom cultivation. Exact recipes, field capacity test, and pasteurization methods.
 11 min read
11 min readCompare laminar flow hoods and still air boxes for mushroom growing. Cost, contamination rates, use cases, and when to upgrade from SAB to flow hood.
 11 min read
11 min readLearn how to cook lion's mane mushroom steaks with our step-by-step recipe. Crispy, golden, and delicious — plus pro tips and variations.
 14 min read
14 min readComplete Martha tent build guide with parts list, assembly, humidifier setup, automation, and troubleshooting for growing mushrooms at home.
 12 min read
12 min readComplete monotub build guide with hole placement, polyfill setup, spawn ratios, colonization, fruiting conditions, and harvesting tips.
 12 min read
12 min readWhich mushrooms are most profitable to grow commercially in Canada? Market prices, yields, grow cycles, and demand analysis for 6 top species.
 12 min read
12 min readIdentify every type of mushroom contamination: Trichoderma, cobweb, Penicillium, lipstick mold, bacteria, and more. Causes, prevention, fixes.
 13 min read
13 min readYour guide to mushroom foraging in BC — best locations, species by region, seasonal calendar, regulations, and sustainable practices for beginners.
 14 min read
14 min readYour guide to mushroom foraging in Ontario — species by season, crown land rules, best locations, safety tips, and essential gear for beginners.
 12 min read
12 min readWeek-by-week mushroom growing timeline for oyster, shiitake, and lion's mane. Know what's normal at every stage from inoculation to harvest.
 13 min read
13 min readComplete guide to making mushroom tea at home. Brewing methods, recipes, and tips for chaga, reishi, lion's mane, and turkey tail teas.
 13 min read
13 min readComplete PF Tek guide for growing gourmet mushrooms. BRF and vermiculite jars, sterilization, inoculation, birthing, fruiting in an SGFC.
 12 min read
12 min readStep-by-step guide to building a still air box for under $15. Learn proper SAB technique for agar work, liquid culture, and inoculation.
 11 min read
11 min readA guide to turkey tail mushroom for dogs — research on immune support, dosage by weight, how to give it, and when to talk to your vet.
 14 min read
14 min readLearn how to grow mushrooms at home in Canada. From grow kits to grain spawn, substrate prep to harvest — everything you need to start.
 13 min read
13 min readStep-by-step guide to growing Lion's Mane mushrooms at home in Canada. Grow kits, grain spawn, and liquid culture methods with troubleshooting tips.
 14 min read
14 min readComplete guide to growing oyster mushrooms at home in Canada. Blue, Pink, Black, and White Oyster methods from grow kits to straw and bucket tek.
 8 min read
8 min readStep-by-step guide to growing shiitake mushrooms on supplemented sawdust blocks — strain selection, colonization, cold shock fruiting, and harvest.
 10 min read
10 min readExplore the research behind lion's mane mushroom benefits — cognitive support, nerve health, gut function. Plus how to choose the right product.
 13 min read
13 min readComplete guide to mushroom substrates — straw, hardwood sawdust, fuel pellets, masters mix. Learn which substrate works best for each species.
 7 min read
7 min readExplore the science behind turkey tail mushroom benefits — from PSK and beta-glucans to gut health. Learn how this Canadian-grown superfood may support immunity.
 7 min read
7 min readDiscover chaga mushroom benefits, from antioxidant power to immune support. Learn about Canada's wild-harvesting tradition and how to use chaga sustainably.
 7 min read
7 min readLearn how reishi mushroom may support better sleep, stress resilience, and immune health. Research, dosage tips, and why evening is the best time to take it.
 7 min read
7 min readExplore cordyceps mushroom benefits for energy, endurance, and VO2 max. Learn the science behind this performance-supporting fungus and how athletes use it.
 8 min read
8 min readComplete guide to mushroom grow bags — filter patches, sizing for grain spawn vs fruiting blocks, sterilization, inoculation, and fruiting techniques.
8 min read
8 min readLearn mushroom agar plate techniques — cloning, strain isolation, contamination testing, and transfers. A complete guide for beginner to intermediate growers.
 4 min read
4 min readAn in-depth look at Hericium erinaceus — the 'smart mushroom' prized for its cognitive benefits, unique texture, and ease of cultivation.
 5 min read
5 min readLearn how to use hardwood fuel pellets as mushroom substrate — cheap, consistent, and nearly sterile right out of the bag.
 3 min read
3 min readSpecies-by-species temperature guide for incubation and fruiting — in Celsius and Fahrenheit — plus tips for Canadian homes.
 5 min read
5 min readTwo proven methods for pasteurizing straw substrate — hot water and cold water lime — with step-by-step instructions.
 4 min read
4 min readCompare mushroom powder, capsules, and tinctures — bioavailability, cost, convenience, and which format suits your lifestyle.
 5 min read
5 min readEverything you need to know about mushroom coffee — what's in it, how it tastes, the benefits by species, and how to brew it.
 3 min read
3 min readMost grow kits produce 2-3 flushes of mushrooms. Learn what a flush is, how to rehydrate between harvests, and maximize your yield.
 5 min read
5 min readThe 5 easiest mushroom species to grow in Canada, ranked — with profiles on each species and why they're great for new growers.
 5 min read
5 min readIdentify, prevent, and deal with Trichoderma (green mold) contamination in your mushroom grows — the most common problem growers face.
 4 min read
4 min readWhat's inside a 5-mushroom blend, why combining species works, who it's for, and how to dose it properly.
 3 min read
3 min readA side-by-side comparison of the two most common ways to propagate mushroom mycelium, and when to use each.
 6 min read
6 min readA practical overview of starting a mushroom farming business in Canada — species selection, facility, equipment, costs, and finding customers.
 4 min read
4 min readMushroom spawn shelf life, storage tips, and how to tell if your spawn is still viable — plus liquid culture longevity.
 6 min read
6 min readTen simple, delicious ways to cook oyster mushrooms — from garlic butter pan-fry to mushroom bacon and creamy risotto.
 6 min read
6 min readComplete guide to growing Pink Oyster mushrooms (Pleurotus djamor) — temperature needs, substrate, harvesting, and Canadian growing tips.
 3 min read
3 min readEverything you need to know to start growing gourmet mushrooms at home — from choosing your first kit to harvesting your first flush.
From your first grow kit to a full cultivation setup — we have everything you need.